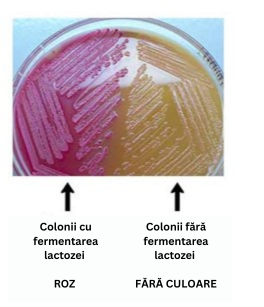

MACDr. Stănescu explică faptul că avem nevoie de un mediu neselectiv în acest caz. MacConkey este selectiv pentru bacteriile Gram-negative datorită prezenței sărurilor biliare și a violetului cristalin, care inhibă bacteriile Gram-pozitive. De asemenea, este selectiv pentru fermentarea lactozei, deoarece duce la o schimbare de culoare.
Deși este eficient pentru identificarea bacteriilor enterice (intestinale) și a coliformilor din alimente, nu este potrivit pentru detectarea prezenței unei game largi de specii bacteriene, deoarece este posibil să nu susțină creșterea bacteriilor Gram-pozitive sau a celor care nu fermentează lactoza. Hai să încercăm din nou!
|
Map: CS11 - CULTURA ȘI CREȘTEREA MICROBIANĂ - ROMANIAN (1053)
|
||
|
Review your pathway |